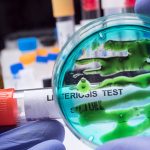

Saturday, January 24, 2026 by Mike Adams
http://www.products.news/2026-01-24-catastrophic-global-consequences-of-us-attack-on-iran.html
The year is 2026. The United States is massing military assets in the Middle East. Europe is warning of “imminent” intervention. American political figures are pressing for a final strike. This article maps the cascading global failure, which starts with the world’s most critical oil chokepoint and ends with the final unraveling of Western economic sovereignty and the acceleration of a BRICS-controlled future.
The Strait of Hormuz is a 30-mile-wide artery of global commerce, yet it carries an existential risk. Every day, 20 million barrels of oil transits this narrow passage, representing a third of the world’s seaborne oil trade and 20% of global supply. It is the ultimate geopolitical tinderbox, and a single spark—a U.S. military strike on Iran—would detonate a global economic crisis far surpassing the 2008 financial collapse.
As recent news confirms, the U.S. military push is real. The aircraft carrier USS Abraham Lincoln and its strike group are reportedly moving to the region, while the U.S. Air Force surges cargo flights and warplanes [1] [2]. American personnel are being withdrawn from key bases, and multiple nations are urgently telling their citizens to leave Iran [3]. The stage is set. This is not a drill; it is the prelude to a catastrophe that would empower globalist centralization at the direct expense of Western sovereignty and economic freedom.
In the opening minutes of any conflict, Iran has vowed a “severe” and “harsh” response to any aggression [4]. The first and most devastating move would be the retaliatory closure of the Strait of Hormuz. This is not speculation; it is a declared and practiced military doctrine. A blocked tanker could instantly cut 40% of shipments, sending global oil prices into uncharted territory [5].
Analysts project an instantaneous spike from today’s $85 per barrel to a staggering $150–$200 range. This would translate to gasoline prices of $12 or more per gallon in the United States. The shock would be absolute. As one analysis notes, the Strait “handles 20 percent of global oil annually, worth $600 billion” [5]. Vaporizing this supply would expose the West’s profound strategic vulnerability, a dependency cultivated by decades of policy that crushed domestic energy production in favor of unreliable foreign sources.
The West’s emergency buffers are a hollow joke. The U.S. Strategic Petroleum Reserve has been depleted to multi-decade lows through politically motivated releases. Europe, still reeling from its self-inflicted dependence on Russian gas, would have no meaningful alternative. The result would be domestic fuel shortages, blackouts, and within days, fuel riots in major cities. The death blow would land on energy-intensive industries like advanced manufacturing and the much-hyped AI sector, whose data centers require massive, uninterrupted power. The climate change narrative, used to justify this domestic energy suicide, would be exposed as the strategic folly it is, having destroyed Western competitiveness just as the ultimate test arrived.
The energy shock is merely the initial tremor of the economic earthquake. Global maritime trade would seize. The Strait of Hormuz is not just for oil; it is a primary corridor for container ships carrying everything from electronics to appliances. A closure would force a wholesale rerouting of global shipping around the Cape of Good Hope, adding weeks to delivery times and doubling or tripling freight costs.
This would replicate but utterly dwarf the supply chain crisis of 2021–22. Critical shortages would emerge overnight: semiconductors, automotive parts, pharmaceuticals, and industrial chemicals. The fragile “just-in-time” inventory model, a monument to globalist efficiency, would collapse into “just-in-case” panicked hoarding.
The most terrifying shortage, however, would be in food. Modern agriculture is entirely dependent on fossil fuels for fertilizer production (natural gas), machinery operation (diesel), and global transport. A fertilizer scarcity, compounded by impossible transport costs, would collapse crop yields globally. Food prices would enter a hyperinflationary spike, creating engineered famine conditions. The elites’ depopulation agenda would advance not through subtle vaccines, but through blunt-force starvation. In this new reality, organic home gardening and community food production cease to be lifestyle choices; they become a necessity for survival. Those who have prepared with heirloom seeds and soil knowledge will have a decisive advantage over those who trusted centralized systems for their daily bread.
Here, the dominoes fall toward the core of the global power structure: the U.S. dollar. A war with Iran would be the catalyzing event for the long-predicted collapse of the fiat dollar system. For decades, the petrodollar—the requirement that global oil trades be settled in dollars—has propped up the currency, enforced by U.S. military might. An attack on Iran, a key BRICS nation, would be the ultimate demonstration of that “weaponized” dollar, triggering a permanent flight from it.
The BRICS+ bloc, led by China and Russia, has been meticulously constructing a parallel financial system for this moment. Their goal is a gold and commodity-backed trade system to bypass the weaponized SWIFT network and the petrodollar. As geopolitical analyst John Mearsheimer notes, even Sunni Gulf states are now pushing back against those advocating regime change in Iran, seeking de-escalation to protect their own economic interests [6]. This signals a profound shift: the world is losing patience with dollar hegemony.
When faith in central bank paper evaporates, capital will rush to the only true safe havens: physical gold and silver. As market reactions to Middle East tensions show, even the hint of conflict sends precious metals soaring as the dollar weakens [7]. In a full-blown war, gold would surge beyond $5,000 per ounce and silver would break all records, validating the timeless worldview that honest, decentralized, counterparty-free money is the only defense against state theft via inflation. The current prices of gold at $4,985 and silver at $103 are merely the calm before the storm.
A U.S. military, bogged down and bleeding in the Persian Gulf, would be an irresistible target for other global powers. The most likely move: a Chinese seizure of Taiwan to secure absolute control over the world’s advanced semiconductor supply. With the U.S. distracted, China could act with impunity, completing a strategic stranglehold on Western technology and critical minerals.
The ensuing domestic chaos—mass migration, stagflation, and social unrest from $12 gasoline and empty shelves—would be the crisis the globalists have long needed. Under the manufactured guise of restoring “stability” and preventing “economic collapse,” they would usher in the final control grid.
Central Bank Digital Currencies (CBDCs) paired with digital IDs would be rolled out as “humanitarian aid” programs. These would not be tools of convenience but instruments of absolute surveillance and control, allowing the state to cut off access to funds for dissenting political views or non-compliance with medical mandates. Enhanced surveillance, justified by “national security,” would become omnipresent. This is the globalist power grab: exploiting the chaos they helped engineer to centralize power permanently in the hands of unaccountable institutions like the WHO, WEF, and BIS, moving the world toward a totalitarian, technocratic state.
The conflict would not end with a ceasefire. It would permanently redraw the world’s economic and technological map. Western industry, already hollowed out, would be crippled by permanently high energy costs and broken supply chains. The dollar, and by extension the Euro and Pound, would be relegated to second-tier status, used only within their depleted domestic economies.
Financial and technological dominance would irreversibly shift to the BRICS+ bloc and its state-controlled, gold-aware financial system. This bloc represents over 40% of the global population and the majority of the world’s natural resources and industrial capacity. As one analysis of BRICS strategy notes, the recent joint naval exercise “Will for Peace 2026” marks a “significant and symbolic evolution” toward a bloc capable of independently securing global trade routes [8].
This represents the final stage of the long-held globalist plan: a weakened, indebted West, fully dependent on foreign supply chains for essentials and controlled by digital currency platforms. Having abandoned the principles of economic freedom, sound money, and national sovereignty, the Western populace would find itself living in a managed decline, a vassal state in a new world order where the BRICS set the rules. Sovereignty would be a memory, and liberty a distant dream.
This scenario is not a paranoid fantasy. It is the logical endpoint of observable trends: the deliberate weakening of domestic energy, the unchecked printing of fiat currency, the aggressive expansion of BRICS, and the relentless push for digital control systems. As events in early 2026 show, the pieces are actively being moved into place [1] [3]. Hope is not a strategy; it is the currency of the doomed.
Individual and community-level preparedness is the only path to preserving liberty and undermining this planned collapse. This means taking tangible steps toward resilience: converting a portion of savings into physical gold and silver, held outside the banking system; learning to grow and preserve your own organic food; securing clean water sources; and building relationships within your local community. Decentralized cryptocurrencies with strong privacy features can provide an alternative to failing banks and surveilled CBDCs.
Knowledge is your primary asset. Seek information from sources that prioritize truth over narrative, such as the uncensored platforms like Brighteon.com for video, Brighteon.social for community, and BrightAnswers.ai for AI-powered research free from globalist censorship. Explore resources like BrightLearn.ai to educate yourself on survival skills, natural medicine, and economic history.
The goal is not just to survive the coming storm, but to build pockets of freedom and abundance that can endure and expand. By decentralizing your life—your food, your energy, your finances, and your information—you withdraw your consent from the failing system and secure your own liberty. In an age of engineered collapse, the most revolutionary act is to become ungovernable by being self-reliant. Start today.
Tagged Under: Tags: Collapse, current events, deception, Dollar Collapse, economic collapse, economy, lies, national security, propaganda, war on Iran

By Willow Tohi
By Laura Harris

By Mike Adams

By Laura Harris

COPYRIGHT © 2017 PRODUCTS NEWS
